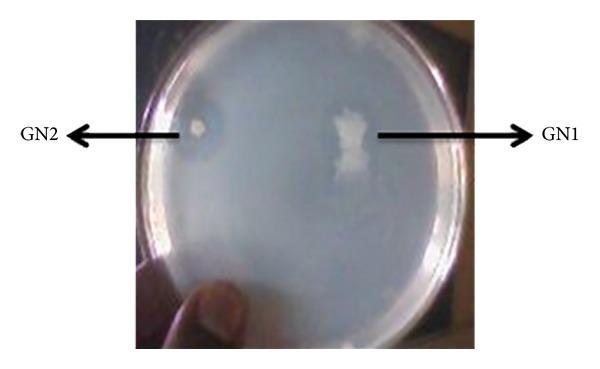
https://cdn.ncbi.nlm.nih.gov/pmc/blobs/a83b/3984769/99e527c0d824/BTRI2014-217030.001.jpg

放线菌产生生物活性化合物及其抗氧化特性。
Production of bioactive compounds by actinomycetes and their antioxidant properties.
作者信息
Janardhan Avilala, Kumar Arthala Praveen, Viswanath Buddolla, Saigopal D V R, Narasimha Golla
机构信息
Department of Virology, Sri Venkateswara University, Tirupati, Andhra Pradesh 517502, India.
出版信息
Biotechnol Res Int. 2014;2014:217030. doi: 10.1155/2014/217030. Epub 2014 Mar 26.
An actinomycete was isolated from mangrove soil collected from Nellore region of Andhra Pradesh, India, and screened for its ability to produce bioactive compounds. The cultural, morphological, and biochemical characters and 16S rRNA sequencing suggest that the isolated strain is Nocardiopsis alba. The bioactive compounds produced by this strain were purified by column chromatography. The in vitro antioxidant capacity of the isolated compounds (fractions) was estimated and fraction F2 showed very near values to the standard ascorbic acid. The potential fraction obtained by column chromatography was subjected to HPLC for further purification, then this purified fraction F2 was examined by FTIR, NMR, and mass spectroscopy to elucidate its chemical structure. By spectral data, the structure of the isolated compound was predicted as "(Z)-1-((1-hydroxypenta-2,4-dien-1-yl)oxy)anthracene-9,10-dione."
从印度安得拉邦内洛尔地区采集的红树林土壤中分离出一株放线菌,并对其产生生物活性化合物的能力进行了筛选。培养、形态和生化特征以及16S rRNA测序表明,分离出的菌株为白色诺卡氏菌。该菌株产生的生物活性化合物通过柱色谱法进行纯化。对分离出的化合物(馏分)的体外抗氧化能力进行了评估,馏分F2显示出与标准抗坏血酸非常接近的值。通过柱色谱法获得的潜在馏分进行HPLC进一步纯化,然后通过FTIR、NMR和质谱对该纯化馏分F2进行检测,以阐明其化学结构。根据光谱数据,分离出的化合物结构预测为“(Z)-1-((1-羟基戊-2,4-二烯-1-基)氧基)蒽-9,10-二酮”。